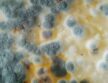

Meddőségi együttműködés
A meddőség és a penészgomba-toxinok közötti kapcsolatot vizsgálják az SE és a MATE kutatói. A mesterséges megtermékenyítés sikerességét akár az élelmiszerekből származó gombatoxinok is befolyásolhatják, hívja fel a figyelmet a Semmelweis Egyetem és a Magyar Agrár- és Élettudományi Egyetem új tanulmánya.
A kutatók a világon elsőként igazolták penészgombák által termelt méreganyagok jelenlétét a humán tüszőfolyadékban és vizsgálták azoknak a termékenységre gyakorolt hatását – tudatták sajtósaik. Fotóink SE/Zellei Boglárka felvételei.
A Semmelweis Egyetem és a Magyar Agrár- és Élettudományi Egyetem közös kutatásának célja az volt, hogy rávilágítson, hogyan befolyásolják a mikotoxinok a tüszők fejlődését és áttételesen hogyan hatnak a megtermékenyülésre. A vizsgálatba 25 lombikprogramban részt vevő pácienst vontak be, akik tüszőfolyadék- és vérmintáit elemezték a leggyakoribb gombatoxinokra.
A tüszőfolyadékban valamennyi vizsgált toxin kimutatható volt, még akkor is, ha a vérmintában nem vagy alacsonyabb koncentrációban voltak jelen. – Eredményeink alapján valószínűsíthető, hogy a follikuláris folyadékban jelen lévő gombatoxinok befolyásolják egyes hormonok működését, a petesejtek minőségét, életképességét, s így a megtermékenyülést – mondja dr. Szentirmay Apolka, a Semmelweis Egyetem Szülészeti és Nőgyógyászati Klinikájának szakorvosa, a tanulmány első szerzője.
Dr. Szőke Zsuzsanna, a MATE Genetika és Biotechnológia Intézet tudományos főmunkatársa, a kutatás társ utolsó szerzője kiemelte, hogy ezen a fontos területen multidiszciplináris szemléletű kutatásokkal, humán- és agrárterületek közös eredményeinek segítségével törekednek az ismeretlen eredetű meddőség okainak feltárására. – A szülészet-nőgyógyászat, embriológia, toxikológia, biotechnológia és az analitika sajátos kihívásaival szembesülve, multidiszciplináris csapatunknak köszönhetően új aspektusból sikerült bepillantást nyerni a tüszőfolyadék gombatoxinok általi kitettségéről és annak a tüszőfejlődésre gyakorolt hatásairól – mondta Szőke doktornő.
A mikotoxinok penészgombák által termelt másodlagos anyagcseretermékek, amelyek mérgező tulajdonságokkal rendelkezhetnek, melyek a mezőgazdasági terményekben és feldolgozott növényi és állati eredetű élelmiszerekben egyaránt előfordulhatnak. Megjelenésük és arányuk az éghajlatváltozás hatására folyamatosan emelkedik. Bizonyos gombatoxinok humánegészségre gyakorolt hatása ismert; például az aflatoxin májdaganatot okozhat. Mindemelett a toxinok befolyásolhatják a hormonrendszer működését is, azonban a humán termékenységgel összefüggésben gyakorolt hatásukat eddig még nem vizsgálták. A meddőség oka sokszor ismeretlen, melynek hátterében a hormonrendszer zavara is állhat.
Az egyik leggyakrabban előforduló ösztrogén-hasonló toxin, a kukoricában is megtalálható Zearalenon, melynek koncentrációja összefüggést mutatott a tüszőfolyadék ösztradiol-tartalmával. Az eredmények alapján feltételezhető, hogy az ösztrogén receptorok számának növelésén keresztül a két hasonló kémiai szerkezetű vegyület egymás hatását erősíti. A Zearalenon az ösztrogén receptorokhoz kötődve csökkentheti a megtermékenyíthető, érett petesejtek számát. Továbbá a mikotoxin közvetlen DNS-károsító, valamint oxidaítv stressz-fokozó hatással is rendelkezik, melyek negatívan befolyásolják az embrió fejlődését.
Egy másik vizsgált toxin, néhány Fusarium penészgomba által termelt Fumonisin B1 kis koncentrációjú jelenléte a tüszőfolyadékban meglepő módon pozitívan hatott a tüszősejtek és a kinyert petesejtek arányára. – Lehetséges, hogy valamilyen védőfunkcióval bír; a mindennapokban is ismerünk penészgomba-származékot, melyet gyógyszerként szedünk, ilyen például a penicillin – magyarázza dr. Sára Levente, a Semmelweis Egyetem Szülészeti és Nőgyógyászati Klinikájának adjunktusa, a kutatás egyik utolsó szerzője.
A tüszőfolyadék összetétele, a benne található komponensek aránya fontos információval szolgál a tüszőérésről. A közeget érő bármilyen negatív hatás közvetlenül hathat a peteérésre és a terhesség kimenetelére. A gombatoxinok a véráramból a tüszőfolyadékba kerülhetnek, ahol gyulladást, oxidatív stresszt és hormonzavart okozhatnak. – Tanulmányunk rámutat, milyen szerepet játszanak a környezeti tényezők a meddőség kialakulásában. További kutatásokkal kiegészítve eredményeink segíthetnek feltárni a meddőség egyes okait és megérteni, pontosan hogyan hatnak a gombatoxinok a női termékenységre – mondta Sára doktor kiemelve, hogy a kockázatok csökkentése érdekében a gombatoxin-szennyezés szorosabb nyomon követése szükséges az élelmiszerláncban.
A kutatás a Richter Kutatási Pályázat RG-IPI-2023-TP17/026 számú és a Magyar Nemzeti Laboratóriumi Projekt, Agrárbiotechnológia és Precíziós Nemesítés az Élelmiszerbiztonsági Nemzeti Laboratórium RRF-2.3.1-21-2022-00007 számú pályázati támogatásával valósult meg.